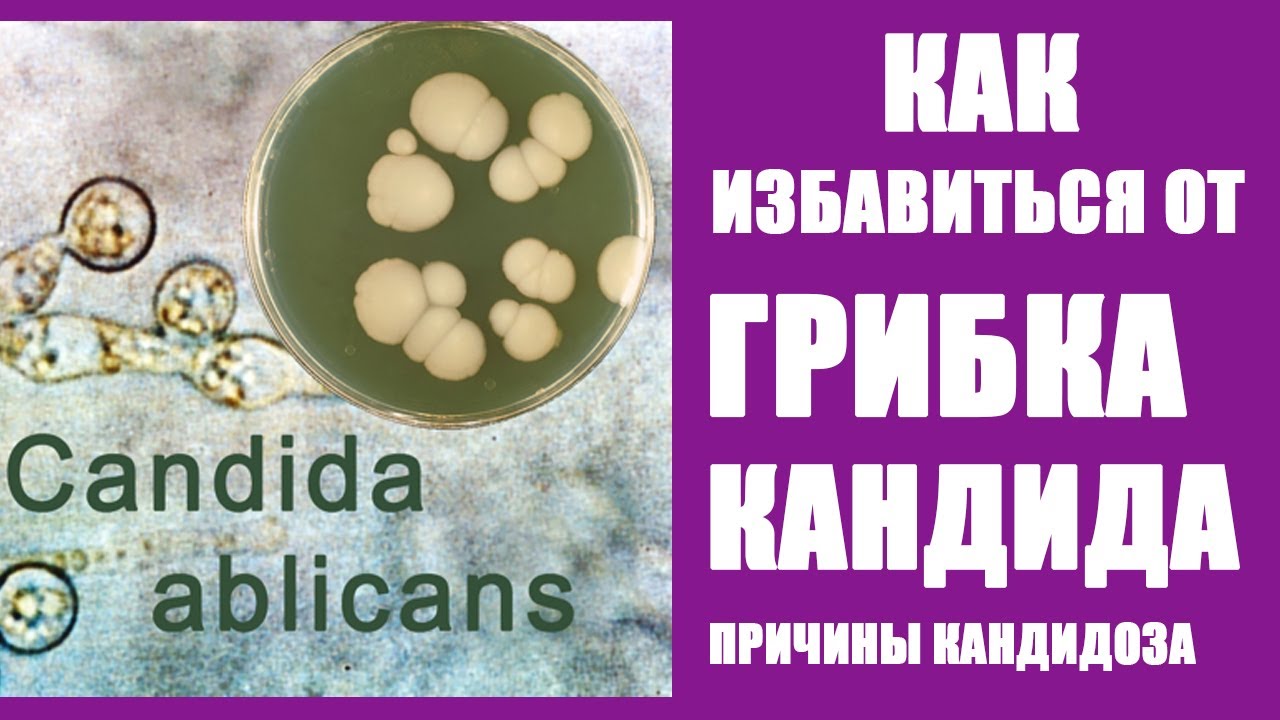

Чего Боится Кандида

🛑 👉🏻👉🏻👉🏻 ВСЯ ИНФОРМАЦИЯ ДОСТУПНА ЗДЕСЬ, ЖМИ 👈🏻👈🏻👈🏻
Купить Энзистал в Гороховеце
Купить Равел СР в Почепе
Купить Лимипранил метро Петровско-Разумовская
Купить Глюкоза в Давлеканове
Чего Боится Кандида

























































































🛑 👉🏻👉🏻👉🏻 ВСЯ ИНФОРМАЦИЯ ДОСТУПНА ЗДЕСЬ, ЖМИ 👈🏻👈🏻👈🏻
Купить Энзистал в Гороховеце
Купить Равел СР в Почепе
Купить Лимипранил метро Петровско-Разумовская
Купить Глюкоза в Давлеканове
Чего Боится Кандида